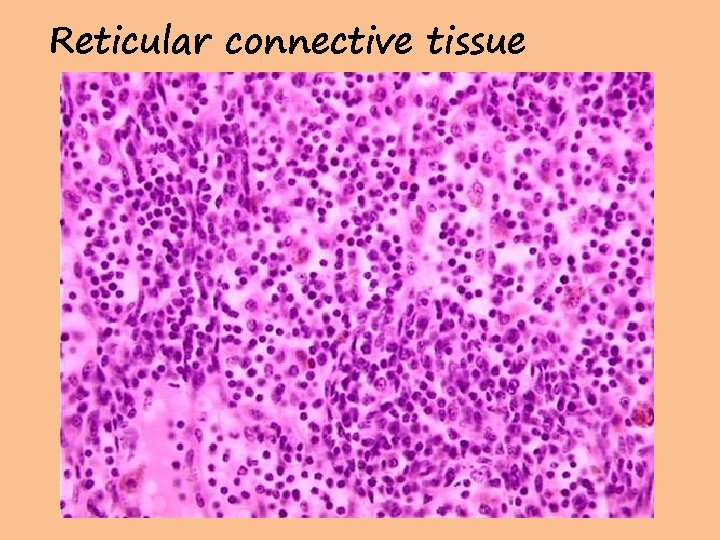
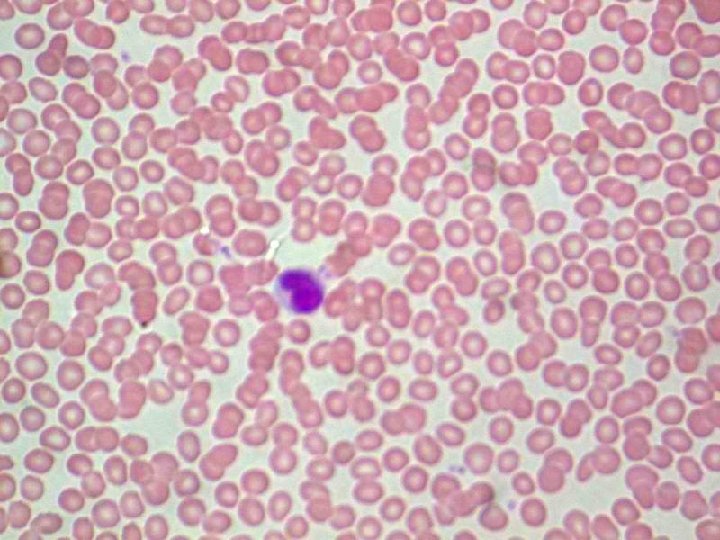
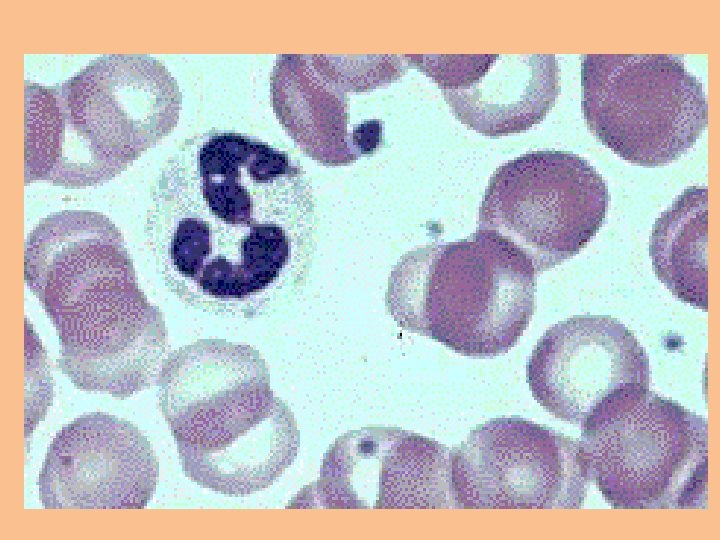
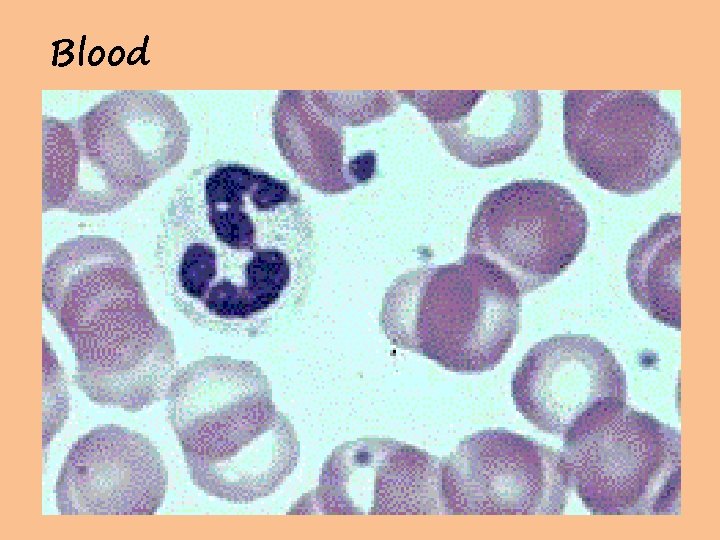
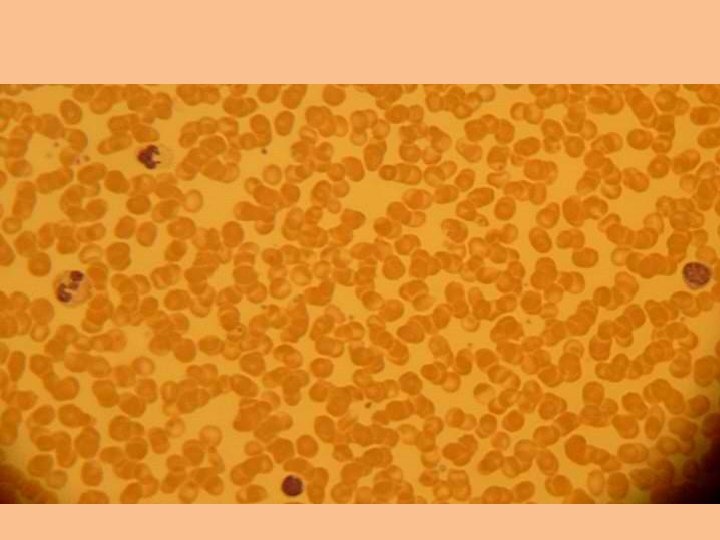
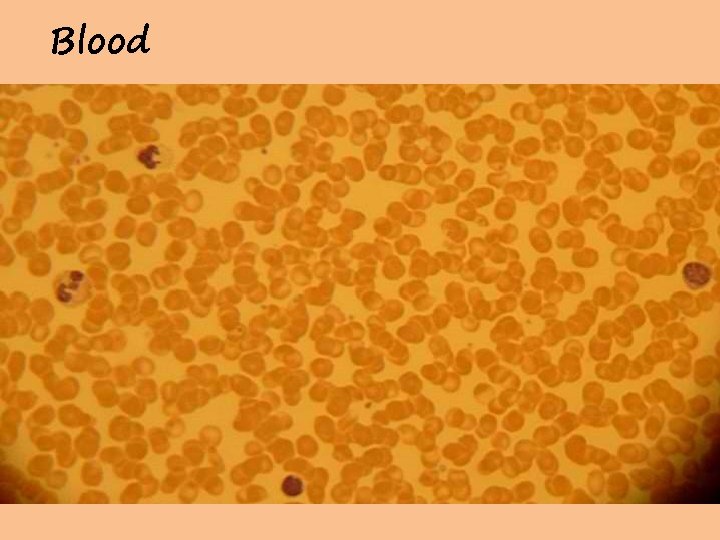
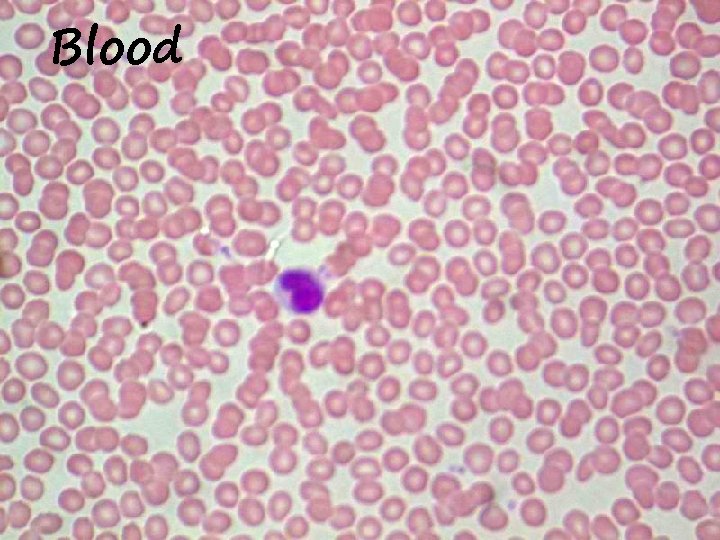
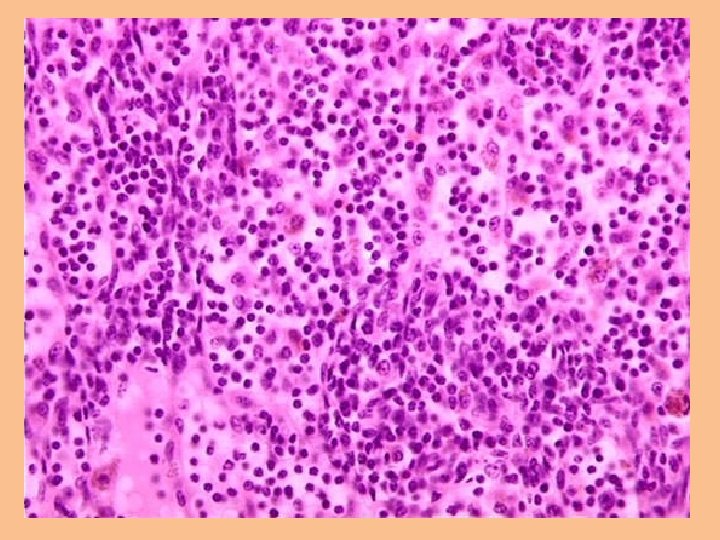

Tissue Practical Practice mixed 2013 Simple cuboidal epithelium

Tissue Practical Practice mixed 2013


Simple cuboidal epithelium


Areolar Connective Tissue


Hyaline Cartilage


Areolar


Skeletal Muscle Tissue


Transitional epithelium


Reticular Connective tissue


Dense Irregular connective


Reticular connective tissue


Nervous tissue


Stratified squamous epithelium

Reticular connective tissue


Nervous tissue

Blood


Nervous tissue


Areolar


Smooth Muscle tissue


Nervous tissue


Bone or Osseous tissue


Transitional epithelium


Simple columnar epithelial tissue


Bone (osseous) tissue


Elastic Cartilage


Fibrocartilage


Hyaline Cartilage


Adipose (fat)


Stratified squamous epithelium


Adipose (fat)


Smooth Muscle tissue


Adipose (fat)

Blood


Simple columnar epithelial tissue

Blood


Dense Irregular connective

Blood


Smooth Muscle tissue


Dense Regular connective


Dense Regular connective


Dense Irregular connective


Cardiac Muscle tissue


Simple columnar epithelial tissue


Cardiac Muscle tissue

What is this?

nucleus

What is this?

Intercalated disc


Cardiac Muscle tissue


Simple cuboidal epithelium


Simple cuboidal epithelium


Transitional epithelium


Transitional epithelium


Pseudostratified epithelium

What is this?

Cilia


Stratified squamous epithelium


Transitional epithelium

What tissue is this?



Simple columnar epithelial tissue

Reticular connective tissue

That’s All for Now!
- Slides: 114